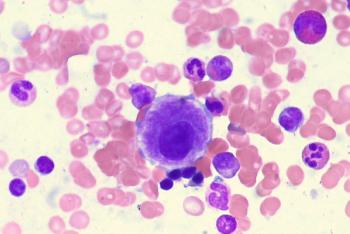

Myelodysplastic Syndromes
Latest News
Latest Videos

CME Content
More News

Lenalidomide capsules and dasatinib tablets have received FDA approval through an abbreviated new drug application for various hematologic malignancies.

Phase 1b data support the potential benefits of R289 as a treatment for patients with lower-risk myelodysplastic syndrome.

In patients with VEXAS Syndrome with or without MDS, ESAs/luspatercept generated positive hematologic improvement-erythroid responses.

The venetoclax regimen improved CR/CRi rates for patients with acute myeloid leukemia and myelodysplastic syndromes.

Minimal tumor lysis syndrome was observed with venetoclax combined with hypomethylating agents in patients with myelodysplastic syndrome.

The IPSS-del(5q) Scoring System shows that factors including male sex, cytopenias, and complex genetic background worsen the prognosis of MDS-del(5q).

For patients with MDS who are relapsed/refractory to erythropoietin stimulating agents, low-dose deferasirox demonstrated promising efficacy and tolerability outcomes.

Smoking may contribute to genetic mutations and disease progression in myelodysplastic syndromes, a recent study found.

The guideline update follows the FDA’s approval of imetelstat in patients with lower-risk MDS based on data from the phase 3 IMerge trial.

The safety profile of oral azacitadine was shown to be similar across the 200-mg and 300-mg arms in patients with lower- to intermediate-risk MDS.

Data from the phase 3 COMMANDS trial support the expanded European approval of frontline luspatercept for transfusion-dependent anemia in lower-risk myelodysplastic syndromes.

Members of the committee reviewed findings from the phase 2/3 IMerge trial assessing imetelstat in patients with transfusion-dependent anemia in myelodysplastic syndromes.

Treatment with rusfertide may reduce the use of phlebotomy and limit debilitating disease-related symptoms in patients with polycythemia vera based on findings from the phase 2 REVIVE trial.

Treatment with imetelstat produces robust activity in patients with relapsed/refractory myelodysplastic syndrome regardless of ring sideroblasts in the phase 3 IMerge trial.

Danazol was reviewed as an effective treatment option for patients with myelodyspplastic syndromes, according to a recently published article by Sangam Shah, MBBS, et al.

The combination of pelabresib plus ruxolitinib shows improvement in hemoglobin response in the MANIFEST-2 trial, supporting a potential shift in the future treatment of patients with JAK inhibitor–naive myelofibrosis.

No patients with myelodysplastic syndrome have any grade 3 or higher acute graft-versus-host disease following treatment with Orca-T in a phase 1b study.

If momelotinib receives approval in the European Union, it will become the only agent for the treatment of myelofibrosis coupled with moderate to severe anemia.

Data from a retrospective study spotlight a need for more effective first-line and second-line clinical management strategies to improve outcomes in patients with lower-risk myelodysplastic syndrome.

Ivosidenib monotherapy is now approved by the FDA for patients with relapsed/refractory myelodysplastic syndrome with an IDH1 mutation.

A real-world study found most patients with lower-risk myelodysplastic syndrome do not appear to require dose escalations of luspatercept.

The marketing authorization application for imetelstat in lower-risk myelodysplastic syndrome is based on findings from the phase 3 IMerge trial.

Characteristics including Ogata score and phenotypic aberrancies may correlate with mutational patterns that are predictive of treatment response in patients with myelodysplastic syndrome.

Luspatercept may provide clinical benefit regardless of subgroup and baseline mutation burden in transfusion dependent patients with myelodysplastic syndrome with anemia, according to Guillermo Garcia-Manero, MD.
Patients with dyserythropoiesis appear to have higher PD-L1 expression than those without in a study population of those with myelodysplastic syndromes.














































